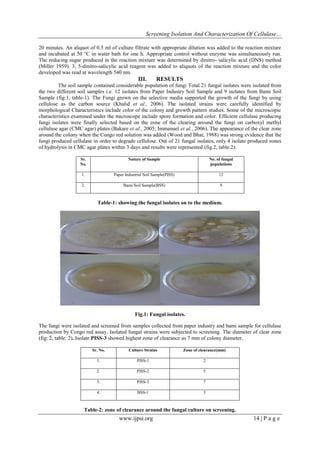
Screening Isolation And Characterization Of Cellulase…
www.ijpsi.org 14 | P a g e
20 minutes. An aliquot of 0.5 ml of culture filtrate with appropriate dilution was added to the reaction mixture
and incubated at 50 °C in water bath for one h. Appropriate control without enzyme was simultaneously run.
The reducing sugar produced in the reaction mixture was determined by dinitro- salicylic acid (DNS) method
(Miller 1959). 3, 5-dinitro-salicylic acid reagent was added to aliquots of the reaction mixture and the color
developed was read at wavelength 540 nm.
III. RESULTS
The soil sample contained considerable population of fungi Total 21 fungal isolates were isolated from
the two different soil samples i.e. 12 isolates from Paper Industry Soil Sample and 9 isolates from Bami Soil
Sample (fig:1, table-1). The Fungi grown on the selective media supported the growth of the fungi by using
cellulose as the carbon source (Khalid et al., 2006). The isolated strains were carefully identified by
morphological Characteristics include color of the colony and growth pattern studies. Some of the microscopic
characteristics examined under the microscope include spore formation and color. Efficient cellulase producing
fungi isolates were finally selected based on the zone of the clearing around the fungi on carboxyl methyl
cellulase agar (CMC agar) plates (Bakare et al., 2005; Immanuel et al., 2006). The appearance of the clear zone
around the colony when the Congo red solution was added (Wood and Bhat, 1988) was strong evidence that the
fungi produced cellulase in order to degrade cellulose. Out of 21 fungal isolates, only 4 isolate produced zones
of hydrolysis in CMC agar plates within 3 days and results were represented (fig.2, table.2).
Sr.
No.
Nature of Sample No. of fungal
populations
1. Paper Industrial Soil Sample(PISS) 12
2. Bami Soil Sample(BSS) 9
Table-1: showing the fungal isolates on to the medium.
Fig.1: Fungal isolates.
The fungi were isolated and screened from samples collected from paper industry and bami sample for cellulase
production by Congo red assay. Isolated fungal strains were subjected to screening. The diameter of clear zone
(fig: 2, table: 2). Isolate PISS-3 showed highest zone of clearance as 7 mm of colony diameter.
Sr. No. Culture Strains Zone of clearance(mm)
1. PISS-1 2
2. PISS-2 5
3. PISS-3 7
4. BSS-1 3
Table-2: zone of clearance around the fungal culture on screening.
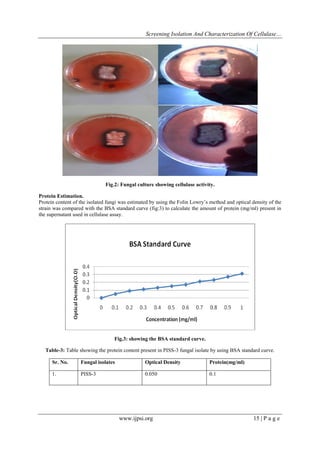
Screening Isolation And Characterization Of Cellulase…
www.ijpsi.org 15 | P a g e
Fig.2: Fungal culture showing cellulase activity.
Protein Estimation.
Protein content of the isolated fungi was estimated by using the Folin Lowry‟s method and optical density of the
strain was compared with the BSA standard curve (fig:3) to calculate the amount of protein (mg/ml) present in
the supernatant used in cellulase assay.
Fig.3: showing the BSA standard curve.
Table-3: Table showing the protein content present in PISS-3 fungal isolate by using BSA standard curve.
Sr. No. Fungal isolates Optical Density Protein(mg/ml)
1. PISS-3 0.050 0.1

The document details the screening, isolation, and characterization of cellulase-producing fungi from soil samples in Himachal Pradesh, focusing on 21 fungal isolates, with four demonstrating cellulase activity. The study emphasizes the industrial importance of cellulases for the hydrolysis of cellulose into glucose, highlighting the potential of these enzymes for various applications. Among the isolates, the strain designated as piss-3 showed the highest cellulase activity, indicating the promising capabilities of fungi in bioconversion processes.

![Screening Isolation And Characterization Of Cellulase…
www.ijpsi.org 18 | P a g e
REFERENCES
[1] Akpan I, Bankole M.O., Adesemowo A.M. and Latunde-Dada G.O., Trop. Sci., 1999, 39, 77-79.
[2] Bakare. M.K., Adewale I.O., Ajayi A., and Shonukan O.O., purification and characterization of a thermostable endoglucanase
from Aspergillus niger, African Journal of Biotechnology, 2005, 9, pp. 898.
[3] Bhat, M.K., Cellulases and related enzymes in biotechnology. In Biotechnology Advances vol.18,2000 pp. 355-383.
[4] Bhat, M.K. and Bhat, S., Cellulose degrading enzymes and their potential industrial applications. Biotechnol Adv., 1997, 15:
583–620.
[5] Chesson A., Supplementary enzymes to improve the utilization of pigs and poultry diets. In: Haresign W Cole DJA editors
Recent advances in animal nutrition London: Butterworths, 1987, 71–89.
[6] Ghose TK., Pure Apple. Chem., 1987, 59, 257-268.
[7] Immanuel, G., Dhanusa, Prema, P., and Palavesam, A., “Effect of different growth parameters on endoglucanase enzyme activity
by bacteria isolated from coir retting effluents of estuarine environment,” International Journal Environment Science
Technology.2006, 3(1), 25-34.
[8] Khalid, Yang, W.J., Kishwar, N., Rajput, Z.I. & Arijo, A.G., Study of cellulolytic soil fungi and two nova species and new
medium. J. Zhejiang Univ. Sci. B, 2006, 7(6): 459-466.
[9] Klemm D, Schmauder H.P., Heinze T., Biopolymers, vol VI, edited by E.Vandamme, S De Beats and A Steinb chel (Wiley-
VCH, Weinheim), 2002, pp. 290 – 292.
[10] Lederberg J., Cellulases. In: Encyclopaedia of Microbiology (Vol. 1; A-C). Academic Press, Inc. 1992.
[11] Lynd LR, Weimer PJ, Van Zyl WH & Pretorious IS, Microbial cellulose utilization: Fundamentals and Biotechnology,
Microbiology. Microbial Mol Bio Rev. 2002, 66: 506-577.
[12] Lone MA, Wani MR, Bhat NA, and Resmi MA., Evaluation of cellulase enzyme secreted by some common and stirring
Rhizosphere fungi of Juglans Regia L. by DNS method. In Journal of Enzyme Research. 2012,Vol 3, issue 1, 18-22.
[13] Nowak, J., Florek, M., Kwiatek, W., Lekki, J., Chevallier, P. and Zieba E, Composite structure of wood cells in petrified wood.
Mater Sci Eng, 2005, C25:119–30.
[14] Subramniyan, S. and Prema, P., Cellulase-free xylanases from Bacillus and other microorganisms. FEMS Microbiol. Lett. 2000,
183: 1-7.
[15] Thomke S., Rundgreen M., Hesselman K. The effect of feeding high-viscosity barley to pigs. In: Proceedings of the 31st meeting
of the European Association of Animal Production, Commission on Animal Production, Munich, Germany. 1980, 5.
[16] Tolan, J.S and Foody, B., Cellulase from submerged fermentation. In: Advances in Biochemical Engineering: Biotechnology Vol
65. Recent Progress in Bioconversion of Lignocellulosics. (Tsao, G.T, Ed.), SpringerVerlag, Berlin, 1999 pp. 41–67.
[17] Teather, R. M., and P. J. Wood. Use of Congo red-polysaccharide interactions in enumeration and characterization of cellulolytic
bacteria from the bovine rumen. Appl. Environ. Microbiol.1982, 43:777-780.
[18] Voragen AGJ, Heutink R, Pilinik W, Solubilization of apple cell walls with polysaccharide degrading enzymes. J Appl Biochem.
1980, 2:452–68.
[19] Voragen AGJ, Wolters H, Verdonschot-Kroef T, Rombouts FM, Pilnik W, Effect of juice-releasing enzymes on juice quality. In:
International Fruit Juice Symposium, The Hague (NL), May 1986. Zurich: Juris Druck Verlag, 1986, 453–62.
[20] Wen , Z., Liao, W. and Chen, S., Production of cellulase by Trichoderma reesei from dairy manure. Bioresour. Technol. 2005,
96: 491- 499.
[21] Wood, T.M. and Bhat, K.M., Methods of measuring cellulase activities. Methods in Ezymology.1988, 160: 87-117.](https://image.slidesharecdn.com/c033012018-140403011029-phpapp02/85/C033012018-7-320.jpg)